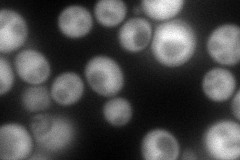
YPR145W
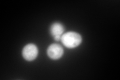
YPR145W
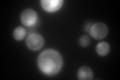
YPR145W
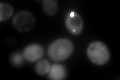
YPR145W

View description
Asparagine synthetase, isozyme of Asn2p; catalyzes the synthesis of L-asparagine from L-aspartate in the asparagine biosynthetic pathway
Localization:
Intensity:
Fold change:
Significance:
-
C’ GFP library in SD

cytosol827.5 -
N' NOP1pr-GFP in SD
cytosol157.11 -
N' TEF2pr-mCherry in SD

cell periphery,vacuole0 -
N' NATIVEpr-GFP in SD

cytosol385.823 -
N' TEF2pr-VC and Cyto-VN in SD

#N/A0 -
C’ GFP library in SD+DTT
cytosol738.90.89No -
C’ GFP library in SD+H2O2

cytosol963.731.16No -
C’ GFP library in Starvation Media
cytosol406.770.49Yes -
C’ GFP library on the background of Pup2-DaMP
punctate -
C’ GFP library on the background of CCT mutant

cytosol845.8421.02216No
